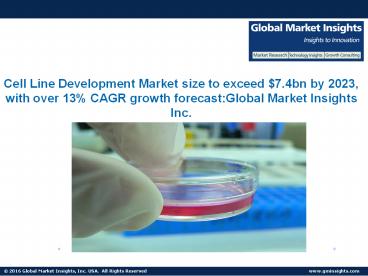
Cell Line Development Market size to exceed $7.4bn by 2023, with over 13% CAGR growth forecast

Cell Line Development Market size to exceed $7.4bn by 2023, with over 13% CAGR growth forecast
https://www.powershow.com/view0/832ba7-YTcwN/Cell_Line_Development_Market_size_to_exceed_7_4bn_by_2023_with_over_13_CAGR_growth_forecast_powerpoint_ppt_presentation
Icons create by Freepik from www.flaticon.com/